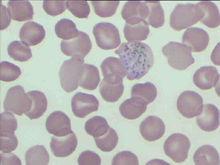
犬巴貝斯焦蟲病
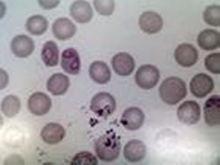
犬巴貝斯焦蟲病

犬巴貝斯焦蟲病
犬巴貝斯焦蟲病
犬巴貝斯焦蟲病 犬巴貝斯焦蟲病
犬巴貝斯焦蟲病犬巴貝斯蟲一般長4~5微米,最長可達7微米。典型蟲體為雙梨籽形,兩蟲尖端以銳角相連,紅細胞內的蟲體數目1——數個不等。
犬巴貝斯蟲的傳播媒介為血紅扇頭蜱、邊緣革蜱、網紋革蜱、美麗革蜱、李氏血蜱和鉛色璃眼蜱。
臨床症狀
 犬巴貝斯焦蟲病
犬巴貝斯焦蟲病犬巴貝斯蟲病,主要表現為高熱,黃疸,呼吸困難。
有些病犬脾臟腫大,觸之敏感。
尿中含蛋白質。
黃疽,食慾下降,乏力,病犬常死於衰竭。
治療:
1,輸血,血型配對後,實行輸血200毫升。
2,對症治療
使用胺基酸、脂肪乳、葡萄糖等營養成分輸液以加強營養,同時口服補血藥物。
3,深部肌肉注射抗寄生蟲藥——貝尼爾(譯音,即血蟲淨),劑量7毫克/公斤體重,每隔3天注射一次,連用三次。此藥毒性較大,注射後該犬體溫升高,達到39.8度,並出現下頜抽動,觸痛敏感等神經症狀,經過對症治療兩天后,諸症狀逐漸消失 。
